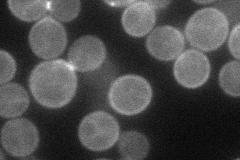
YOR233W

View description
Serine/threonine protein kinase that inhibits the mitotic exit network (MEN) when the spindle position checkpoint is activated; localized asymmetrically to mother cell cortex, spindle pole body and bud neck
Localization:
Intensity:
Fold change:
Significance:
-
C’ GFP library in SD

cell periphery27.3 -
N' NOP1pr-GFP in SD
cell periphery,bud56.1323 -
N' TEF2pr-mCherry in SD

cell periphery0 -
N' NATIVEpr-GFP in SD

cytosol29.0729 -
N' TEF2pr-VC and Cyto-VN in SD

#N/A0 -
C’ GFP library in SD+DTT

cell periphery23.720.86No -
C’ GFP library in SD+H2O2

cell periphery26.430.96No -
C’ GFP library in Starvation Media

cell periphery20.060.73Yes -
C’ GFP library on the background of Pup2-DaMP

cell periphery -
C’ GFP library on the background of CCT mutant

cell periphery28.01151.02571No
